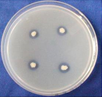
ABIImage

About Agri-Business Incubation Center, ICAR-NSRI, Indore
Objectives
- To create, nurture, strengthen, and incubate startups and entrepreneurs in commercial production and formulation of bio-inoculants (AM fungi, bacterial strains) of NSRI microbial technologies for use in soybean and other crop/plants.
- To create, strengthen, and incubate startups and entrepreneurs in the area of the soybean food processing sector.
- To provide incubation support for access to knowledge and networking services in innovation and developing entrepreneurship and business plans in biofertilizer production, soybean food processing, seed production and fabrication of farm machineries.
- Click More About ABI
- Click More About ABI
Agri-business opportunities for startups and companies
Production of biofertilizers and bioinoculants based technologies viz.,
|
![]() ![]() |
Soybean food product based technology viz.,
|
|
|
|
Mentoring in fabrication of farm implements for soybean farming viz.
|
|
|
|
Registration under ABI
These programs, in collaboration with state governments, train farmers and women entrepreneurs from regions like Maharashtra and Madhya Pradesh. We focus on simple, low-cost technologies for products like soy flour, tofu, and snacks, helping them create sustainable livelihoods and improve local nutrition .
The applicants and startups, has to mandatorily register as incubatee at ABI Centre ICAR- NSRI, Indore for incubation with registration fee on Rs. 2000/- only
(Click here for Registration)
(Click here for Registration).
Initially, the duration of incubation will be 1 month which may be extended for 3 months or more in the specific case depending on requirement and in accordance with MoA/MoU.
|
Course Fee |
| Engagement of incubates, startups for mentoring/incubation and funding facilitation in soy food processing and byproduct utilization and production of microbial bioinoculants | Rs.30,000/-for six months towards rent, infrastructure facilities and mentoring fee for soy food processing/biofertilizer production/seed business (sitting space for two persons/startup) |
| Certified sensitization training in soy food processing and by product utilization Programme (TSFP) for Startups, individuals, entrepreneurs, industry representatives, FPOs and SHGs. |
Rs.5500/- for self-sponsored for 5 days Entrepreneurs Development Programme (minimum batch of 10 trainees)* Rs1500/-for farmers/FPOs minimum of 10 farmers for 3days Rs.5000/-for individuals sponsored by companies/industries/Govt. Organizations for two days. |
| Five days certified training on practicing basic techniques of arbuscular mycorrhizal fungal biofertilizer Programme (TAMP) and bacterial bio-fertilizers. |
CourseFee:Rs.15000/-(for self-sponsored)* CourseFee:Rs.30000/-(for candidates sponsored by companies/industries/Govt. Organization)* |
| Other skill-based training |
One-day sensitization workshop cum training on quality seed production of soybean varieties (including specialty food grade soybeans): Course Fee-Rs. 1000/- (for self-sponsored) and Rs 2000/- for candidates sponsored by companies/industries/Govt. Organization* Five days customized training on soil nutrient analysis in soil: Course fee-Rs. 5000/- for self- sponsored) and Rs 10,000/- for candidates sponsored by companies/industries/Govt. Organization One day hands on training on soy food uses for capacity building and empowerment of rural Men/women: Course Fee-Free of cost |
Training provided by ABI, ICAR-NSRI, Indore
|
Course Fee |
|
Five days Entrepreneurs Development Programme (EDP)(minimum batch of 10 trainees)
Apply |
Rs. 5500/- (for candidates sponsored by companies/industries/Govt. Organization) |
|
Five days certified training on practicing basic techniques of arbuscular mycorrhizal fungal biofertilizer Programme (TAMP) and bacterial bio-fertilizers
Apply |
Rs. 15000/- (for self-sponsored)
Rs. 30000/- (for candidates sponsored by companies/industries/Govt. Organization) |
|
One day sensitization workshop cum training on quality seed production of soybean varieties (including specialty food grade soybeans) (TQSP)
Apply |
Rs. 1000/- (for self-sponsored)
Rs 2000/ (for candidates sponsored by companies/industries/Govt. Organization) |
|
Five days customized training on soil nutrient analysis in soil:(TSNA)
Apply |
Rs. 5000/- (for self-sponsored)
Rs 10,000/- (for candidates sponsored by companies/industries/Govt. Organization) |
|
Five days customized training on lipid profiling in soil(TLPS)
Apply |
Rs 30,000/- (for candidates sponsored by companies/industries/Govt. Organization) |
Eligibility of Applicants
- Any start up/ Firms/ companies/ NGOs/ GOs or prospective startup/individual and companies engaged in microbial biofertilizer, soy food processing, farm implement fabrication, analytical services and seed production can get associate with ICAR-NSRI-ABI, Indore Centre after completing admission/registration formalities.
- The individuals who have already registered their firm under company’s registration act and are looking for facilities/infrastructure for their start-up.
- Aspiring individuals who have are seeking technical mentoring to start the startup and entrepreneurship in any of the sector mentioned above.
- The ABI Centre has a special focus on empowering women-led enterprises, Farmer Producer Organizations (FPOs), and Self-Help Groups (SHGs). We have specially designed a three-day hands-on training program focused on training and empowering FPOs and SHGs. We have also signed MOUs with various FPOs for discounted rates on training. Our simple, low-cost technologies are designed to create sustainable livelihoods and improve community nutrition.
Contact Us
Your Success Story Starts Here. Join the ABI Program Today!
Ready to launch your venture in 2025?
Contact us to join the next wave of soy innovation.
In charge
Agri Business Incubation Centre
ICAR-National Soybean Research Institute (NSRI)
Khandwa Road, Indore-452001, (M.P.), India
Email: iisr.abi.soybean@gmail.com;dsriprind@gmail.com
Tel: 0731-2437954